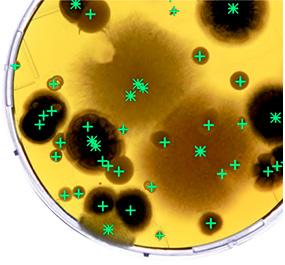

SCANDIAGNOSTIC


![]()

ScanStation® är en inkubator och koloniräknare i realtid, som inkluderar inkubering, detektering och räkning av 100-300 petriskålar samtidigt.
Kameran på 5 megapixel tar bilder av alla petriskålar var 30:e minut. Inkubationstemperaturen kan ställas in på mellan 20 och 45 grader.
Scandinavian Diagnostics kan erbjuda 3 olika modeller av ScanStation, så det finns gott om möjligheter att hitta en som passar dina behov. En nyhet är att skärmen på ScanStation® är placerad i mitten av instrumentet, så den bredd som krävs har minskats från 245 cm till 175 cm.
För att underlätta åtkomsten till botten av karusellen, vid rengöring och desinfektion, är de 5-bladiga blocken fästa magnetiskt, för enkel borttagning. Ytan under karusellen kan enkelt rengöras.

Avancerad räkning
• Förbättrad räknealgoritm genom bildfusion (patenterad) och optimering av kantdetektering
• Mögeldetektering av AI-neuralt nätverk
• Analys av filtreringsmembran av alla slag
Förbättrad användarupplevelse
• Visualisering av statistiska resultat
• Omedelbara meddelanden om meddelanden: temperaturförändringar, räknegränser överskridna
• Automatisk lansering av inkubationscykel
Anslutning på distans
• Mobilapp och fjärrvy av resultat
• Fjärråtkomst via nätverket för validering av resultat
• LIMS-anslutning: i webbtjänst eller fildelning Ökad säkerhet


Mono eller flera batcher
Insättning av petriskålar kan göras i början eller under inkubationen, med olika ljus- eller inkubationstidsinställningar. Till exempel kan 70 kontaktplattor fyllas på dag 1 av 5 dagars inkubation. På dag 2 tillsätts 20 st 90 mm petriskålar för 2 dagars inkubation. Därmed kan flera satser, med olika inställningar, analyseras tillsammans.
Den högpresterande telecentriska linsen gör att du kan se petriskålen i absolut vertikalt läge utan perspektivförvrängning. Ytan runt skålens kant, där agarmediet gör det svårare att räkna, minskar. Genom att minska denna yta från 9 % till 5 % av petriskålens totala yta optimeras den typiska räknenoggrannheten från 95 % till 97,5 %. Detta är avgörande för läkemedelsindustrin, där en koloni på kanten av skålen kan göra skillnaden mellan ett positivt eller negativt resultat, särskilt vid övervakning av luftkvaliteten i renrum. Den här nya funktionen är standard på ScanStation 300-modellen.



Camilla Larsson camilla.larsson@scandiagnostics.se
Tlf: 031-792 20 24
Den integrerade streckkodsläsaren kan läsa de flesta 1D/2D-streckkoder på marknaden, inklusive QR-koder och datamatrix. När det används i kombination med en spiral® platta kan Intersciences dataLink™-system också användas för att överföra data från plattan till ScanStation®. På så sätt undviks dubbel datainmatning och risk för fel.
Inkubation och detektion
ScanStation® använder peltierelementet, vilket säkerställer en konstant och stabil temperatur. Ultra-HD-kameran på 5 megapixlar upptäcker kolonier så snart de dyker upp, innan klusterbildning eller tillväxt över huvudet kan inträffa, samtidigt som icke-relevanta kolonier separeras. Detta ger mer exakta och snabbare resultat. Det är möjligt att läsa både ingjutna kolonier, ytspridda kolonier (även utsådd med easySpiral® diluter och med filtreringsmembran).
Att mäta syre i förpackade livsmedel enligt
MAP (Modified Atmosphere Pack) är viktigt, eftersom syrekoncentrationen har stor inverkan på livsmedelssäkerhet, kvalitet och hållbarhet.

Varför mäta syre i MAP-förpackningar?
1. Förhindra mikrobiologisk tillväxt:
• Höga syrekoncentrationer kan främja tillväxten av aeroba mikroorganismer, vilket kan leda till nedbrytning.
Låga syrenivåer kan förhindra tillväxten av sådana mikroorganismer, men samtidigt måste det balanseras för att inte skapa gynnsamma förhållanden för anaeroba patogener som Clostridium botulinum.
2. Bevara matens kvalitet:
Syre kan leda till oxidation av lipider, vilket orsakar härskning av feta livsmedel.
• Kan också påverka färg och konsistens, särskilt i köttprodukter.
3. Efterlevnad av lagstiftning och standarder:
Livsmedelsföretagare måste dokumentera att MAP-processen fungerar korrekt och att förpackningarna innehåller den deklarerade gasblandningen (t.ex. låg syrehalt och hög CO₂- eller kvävehalt).
I de flesta fall kommer syrehalten i gasen i MAP-förpackningar att vara en viktig kontroll i företagets riskanalys. Därför är det viktigt att kunna mäta det.
Lagstiftning om MAP:
I Sverige och EU regleras användningen av MAP i livsmedelslagstiftningen, främst:
1. Förordning (EU) nr 1169/2011 (Livsmedelsinformation till konsumenterna)
• Kräver att förpackningen anger om modifierad atmosfär används (t.ex. "Förpackad i skyddande atmosfär").
2. Hygienföreskrifterna (EG nr 852/2004 och 853/2004)
• Reglerar hanterings- och hygienkrav vid produktion och förpackning av livsmedel, inklusive MAP.
5. Gasblandningar och kontakt med livsmedel
• Endast gaser som är godkända som livsmedelstillsatser (t.ex. kväve, CO₂ och syre) får användas. Dessa regleras i förordning (EG) nr 1333/2008.
MAP måste användas på rätt sätt och kontrolleras noggrant för att upprätthålla livsmedelssäkerheten och säkerställa att tillämplig lagstiftning följs.




Hur används en restsyremätare?
Bärbar syremätare:
• Lätt att använda direkt på produktionslinjen eller på färdigvara.
• Ofta med nålsonder för punktering av packningar och mätning av den inre atmosfären.
Stationär syremätare:
• Kan integreras i förpackningslinjer för kontinuerlig övervakning.
Noggrannhet och känslighet:
• Mätaren måste kunna mäta syrekoncentrationer i det låga intervallet (vanligtvis < 1 % i MAP-förpackningar).
ResOX 5696 restsyremätare
Restsyremätare för exakta mätningar över eller under 35 % O2 beroende på sensor
Snabba och tillförlitliga mätningar på mindre än 20 sekunder.
Säkerställer livsmedelssäkerhet enligt HACCP
Enkel kalibrering på plats av instrumentet säkerställer daglig funktionalitet
Enkel dokumentation av process och provtagning – lagras i instrumentet eller kan överföras till PC–
Underhållskostnaderna är minimala eftersom instrumentet är inbyggt i flera oberoende delar som kan bytas ut separat.
Erik Björkegren erik.bjorkegren@scandiagnostics.se
Tlf: 031-792 20 25

Fördelar:
CDR BeerLab® är ett avancerat, användarvänligt analysverktyg designat specifikt för bryggerier som vill optimera kvaliteten och effektiviteten i sin produktionsprocess. Systemet gör det möjligt för bryggare att snabbt och noggrant utföra kemiska analyser av öl, cider och relaterade drycker – både under produktion och i den färdiga produkten.
Med CDR BeerLab® kan man övervaka nyckelparametrar som alkoholhalt, bitterhet (IBU), färg, pH, sockerhalt med mera. Den snabba analystiden och enkla driften gör det möjligt för bryggerier att fatta datadrivna beslut på plats och minimera slöseri och fel.
Utrustningen kräver ingen specialiserad laboratorieerfarenhet, vilket gör den till en idealisk lösning för bryggerier som vill ha hög kvalitet utan att investera i dyr laboratorieutrustning. CDR BeerLab® kombinerar precision med funktionalitet, vilket gör den till en värdefull partner i jakten på den perfekta bryggningen.
Reducerad Analystid
Med CDR Beerlab® kan du själv utföra analyserna på bryggeriet, snabbt och smidigt utan att vänta på ett externt labb. Det är möjligt att analysera 16 olika tester samtidigt och ger en omedelbar övervakning av produktionsprocessen med konkreta och precisa svar på få minuter.
Smidig hantering
Systemet är designat så, att det inte bara kan användas på labbet, utan även i produktionen med svar i realtid. Analysmetoden, som visas i displayen, är enklare än traditionella metoder och kan utföras i några få steg. Om det är nödvändigt finns även en hjälp-funktion som guidar operatören steg för steg genom processen. Resultatet blir beräknat, visat på displayen och utskrivet på papper.
Pålitligt
CDR Beerlab®garanterar hög känslighet, ett bred mätområde och utmärkt repeterbarhet av resultaten tack vare den innovativa fotometriska teknologin, som använder LED-ljuskällor och fasta våglängder som spänner från ultraviolett till det synliga spektrumet (i ett område mellan 0 till 6 i optisk täthet). Analyserna är korrelerade med referensmetodernas.
CDR BeerLab® finns i två varianter:
1. CDR BeerLab®, där 16 kyvetter kan analyseras samtidigt och har inbyggd skrivare.
2. CDR BeerLab® Jr. för 3 kyvetter åt gången. Möjlighet till extern skrivare.

Vatten – den kanske viktigaste ingrediensen
Vatten är en av de viktigaste ingredienserna i ölbryggning och utgör vanligtvis 90-95 % av det färdiga ölet. Detta gör att vattnets kvalitet och sammansättning har en direkt inverkan på både smak, arom och stabilitet hos den färdiga produkten.
CDR BeerLab® kan analysera 8 olika parametrar på vattnet och är därför ett fantastiskt verktyg i jakten på den perfekta brygden.

Varför är analys av bryggvatten avgörande?
1. Mineralinnehåll och smak
Vattnets mineraler, som kalcium, magnesium, sulfater och bikarbonater, påverkar ölets smakprofil. Till exempel framhäver sulfater humlekaraktären, medan bikarbonater kan göra smaken mer bitter eller skarp. Att känna till mineralinnehållet gör det möjligt för bryggaren att anpassa vattnets sammansättning för att passa den önskade typen av öl.
2. pH-värde och mäskning
Rätt pH i mäskningen (typiskt mellan 5,2 och 5,6) är avgörande för enzymaktiviteten som omvandlar stärkelse till socker. Vattnets naturliga pH och buffrande kapacitet kan påverka mäskens effektivitet och i slutändan ölets smakbalans.
3. Förebyggande av oönskade smaker
Föroreningar som järn, klor eller organiska föreningar i vattnet kan leda till oönskade smaker och aromer i det färdiga ölet. Analys av vattnet gör det möjligt att identifiera och ta bort sådana ämnen, t.ex. genom filtrering eller kemisk behandling.
4. Konsekvens i produktionen
Se video om CDR
BeerLab® här:

Konsekvent kvalitet och smak är avgörande för kundnöjdhet. Genom att kontinuerligt analysera och justera vattnet kan bryggerier säkerställa en konsekvent bryggning, även om vattentillgången varierar i mineralhalt över tiden.
Kontakta vår produktspecialist för mer information
Kontakt vores produktspecialister for mere information
Thomas Bundgaard
Katarina Petrucic
thomasb@fooddiagnostics.dk
Katarina@fooddiagnostics.dk
Tlf: 4268 7218
Tlf: 25 94 80 86
Ät dig till värmen
Stark mat som peppar och chili får sin karakteristiska smak från specifika kemiska föreningar som aktiverar smärt- och värmereceptorer i munnen och på huden.
Biokemi
Chilipeppar och capsaicin
Danmark
Cristiana@foodiagnostics.dk Telefon: 2594 8086
Hälsoaspekter
Berikade livsmedel är förknippade med flera hälsofördelar, inklusive:
Runi Nielsen
Færøerne
• Chili får sin styrka från capsaicin och relaterade ämnen som kallas capsaicinoider. Capsaicin binder till en receptor i kroppen som kallas TRPV1. TRPV1 upptäcker värme och smärta. När capsaicin aktiverar denna receptor känns det som att munnen brinner, trots att det inte finns någon verklig temperaturförändring.
Svartpeppar och piperin

Tonny Nielsen

Hygiejne & ECA
• Förbättrad ämnesomsättning: Capsaicin kan öka energiförbrukningen och främja fettförbränningen.
Ehsan Mirsharghi
Mikrobiologi
Runi@foodiagnostics.dk Telefon: (298) 591667
Danmark
Den starka smaken i svartpeppar beror på en alkaloid som kallas piperin. Piperin är mindre intensiv än capsaicin, men det bidrar till en mild, varm och skarp smak.
Senap, pepparrot och wasabi
Dessa livsmedel får sin skarphet från isotiocyanater, som bildas när enzymer bryter ner glukosinolater som finns naturligt i växter. Isotiocyanater påverkar receptorer i näsa och svalg, vilket ger en "uppfriskande" skarphet som ofta upplevs som en kortvarig stickande känsla.
Danmark
• Antiinflammatoriska egenskaper: Piperin och capsaicin har visat sig ha antiinflammatoriska effekter.
Tonny@foodiagnostics.dk Telefon: 4056 5659
Ehsan@foodiagnostics.dk Telefon: 2222 7592
• Antioxidantaktivitet: Många av dessa föreningar fungerar som antioxidanter som kan skydda celler från skador.
Stark mat är därför mer än bara smak – de representerar en fascinerande kombination av kemi och fysiologi som både utmanar och belönar våra sinnen!

Det är nu möjligt att förregistrera ditt instrument online för verifiering, kalibrering eller service.
Läs mycket mer på vår hemsida.

WEBBINARIER 2025
Vi håller regelbundet webbinarier. Se nästa webbinarium här:
• ATP, 20.03.2025
• Allergener 9.4.2025
• Compact Dry 14.5. 2025
Skanna QR-koden och läs mer:



Scandinavian Diagnostics AB Norra Ågaten 10 41664 Göteborg Sverige
Tlf: 031-792 2020
Mail: order@scandiagnostics.se
och anmäl dig till vårt digitala nyhetsbrev eller 'följ' oss på Facebook och LinkedIn

